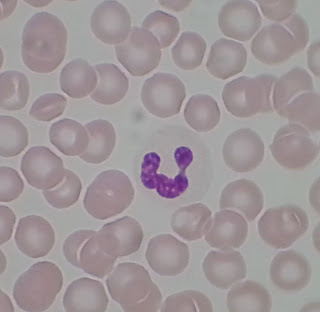

Today's Medical Topic: Histology of Blood Part Deux.
The Tissue Sample: Agranulocytes. If you guessed that agranulocytes have no granules in them then you are a genius, sir and/or madam, and you have no business reading this blog.
Agranulocytes all arise from ancestral stem cells, however, unlike granulocytes, agranulocytes do not all come from a myeloid stem cell. A monocyte arises from a myeloid stem cell and lymphocytes arise from a lymphoid stem cell. Lets take a look.
Next up...something. Something else about blood.
Agranulocytes all arise from ancestral stem cells, however, unlike granulocytes, agranulocytes do not all come from a myeloid stem cell. A monocyte arises from a myeloid stem cell and lymphocytes arise from a lymphoid stem cell. Lets take a look.
![]() |
| 1000x magnification |
This is a monocyte
- Has a kidney-shaped nucleus with an "invagination" which is what the red arrow is pointing to.
- Is more than three times larger than a red blood cell.
- Monocytes are the bad boys of the cell world they develop into macrophages and eat stuff.
- Macrophages can engulf and break down almost anything they can fit inside them.
![]() |
| 1000x magnification |
This is a lymphocyte
- Has a spherical nucleus.
- Is about the same size as a red blood cell
- Comes in several flavors but lymphocytes mount immune response by direct cell attack or by synthesizing antibodies.
Next up...something. Something else about blood.
Send questions or comments to dudaday@gmail.com
Disclaimer: I am not a health care provider, any information presented in this blog should not be considered advice it is mearly an outlet to slake my curiosity. You should always consult your primary medical provider for any concerns or illness. Unlike Tylenol, I am not approved by the FDA or American Medical Association to treat or provide relief for any ailment.